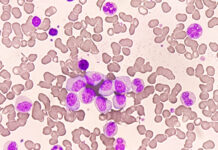
Bexobrutideg Produces Rapid and Durable Responses in CLL

A team from Italy shared their experience integrating a digital health platform to improve care of patients suspected to have acquired hemophilia A (AHA). The platform connects hospitals, laboratories, community pharmacies, and the hemophilia center to enhance disease management from diagnosis through treatment.
“This digital platform could serve as a blueprint for managing other rare diseases by bridging gaps between specialized centers and peripheral care providers, fostering innovation and systemic improvement in rare disease care delivery,” wrote the authors, led by Marta Mattana of the University of Palermo, Italy. “The integration of clinical expertise, real-time data exchange, and patient engagement has the potential to significantly improve diagnosis, treatment, and long-term monitoring of AHA patients.”
AHA is a rare but potentially life-threatening bleeding disorder caused by autoantibodies that neutralize coagulation factor VIII. Because the condition is rare, patients often experience diagnostic delays, suboptimal treatment, increased morbidity and mortality, and high costs, the authors explained.
They launched a project to develop a digital platform to facilitate remote interactions among patients, clinicians, pharmacists, biologists, clinical pathologists, and nurses. The platform is designed so that all participating sites can enter and share data, “ensuring the patient’s clinical information is accessible in real time by specialists at the reference center as well as by local healthcare professionals.”
Specifically, the platform provides the following benefits:
- Emergency departments and general practitioners have access to hemophilia experts.
- Healthcare providers can access and interpret laboratory results.
- Clinicians can make therapeutic adjustments based on real-time clinical and laboratory data.
- Patients can contact members of the healthcare team.
The platform went into effect in February 2025, and early analysis indicates success. Four physicians from four community hospitals have joined the network (two from emergency departments and two from hematology units). A total of 12 consultations have been made via the platform for suspicion of AHA, and the platform has been used in the management of two patients (one in an emergency department and one in a hematology unit). Both patients achieved complete remission. The authors emphasized that all data are protected in a manner that complies with privacy regulations and security protocols.
“Six months after its availability, the platform underscores its potential to streamline care, reduce inappropriate interventions, and enhance communication across all levels of the healthcare systems,” the authors concluded.
Reference
Mattana M, Cammarata C, Siragusa S, et al. Innovating rare disease care: A digital health network for the remote management of acquired Hemophilia A. Abstract abs25-14482. Presented at: the 67th American Society of Hematology Annual Meeting and Exposition, Dec. 6-9, 2025, Orlando, FL.